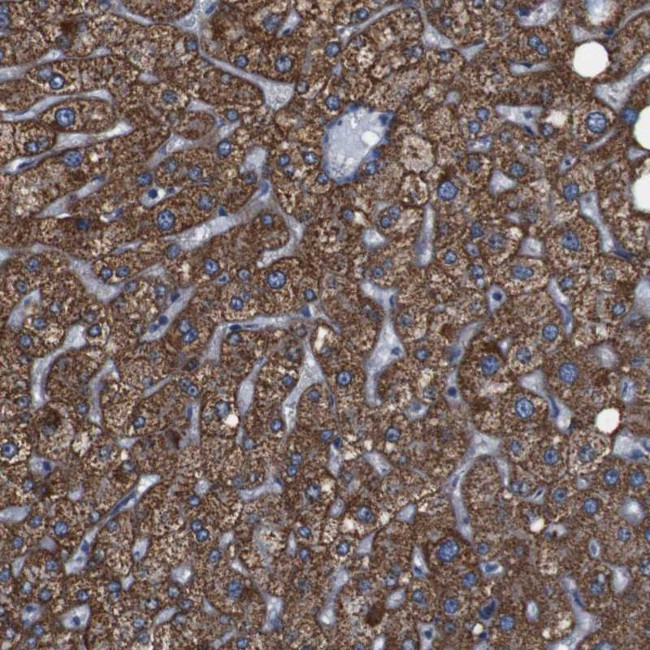
GGT7 Antibody in Immunohistochemistry (Paraffin) (IHC (P))

Search
Invitrogen
GGT7 Polyclonal Antibody
{{$productOrderCtrl.translations['antibody.pdp.commerceCard.promotion.promotions']}}
{{$productOrderCtrl.translations['antibody.pdp.commerceCard.promotion.viewpromo']}}
{{$productOrderCtrl.translations['antibody.pdp.commerceCard.promotion.promocode']}}: {{promo.promoCode}} {{promo.promoTitle}} {{promo.promoDescription}}. {{$productOrderCtrl.translations['antibody.pdp.commerceCard.promotion.learnmore']}}
产品信息
PA5-53035
种属反应
已发表种属
宿主/亚型
分类
类型
抗原
偶联物
形式
浓度
规格
纯化类型
保存液
内含物
保存条件
运输条件
RRID
产品详细信息
Immunogen sequence: HLVLSPPPPH TGPALISALN ILEGFNLTSL VSREQALHWV AETLKIALAL ASRLGDPVYD STITESMDDM LSKVEAAYLR GHINDSQAAP APLLPVYELD GAPTAAQVLI MGPDDFIVAM VSSLNQPFGS GLITPSGILL NS
Highest antigen sequence identity to the following orthologs: Mouse - 96%, Rat - 95%.
靶标信息
GGTL3 is an enzymes involved in both the metabolism of glutathione and in the transpeptidation of amino acids. Changes in the activity of gamma-glutamyltransferase may signal preneoplastic or toxic conditions in the liver or kidney. GGTL3 consists of a heavy and a light chain, and it can interact with CT120, a plasma membrane-associated protein that is possibly involved in lung carcinogenesis.This gene is a member of a gene family that encodes enzymes involved in both the metabolism of glutathione and in the transpeptidation of amino acids. Changes in the activity of gamma-glutamyltransferase may signal preneoplastic or toxic conditions in the liver or kidney. The protein encoded by this gene consists of a heavy and a light chain, and it can interact with CT120, a plasma membrane-associated protein that is possibly involved in lung carcinogenesis.
仅用于科研。不用于诊断过程。未经明确授权不得转售。
生物信息学
蛋白别名: gamma-glutamyltransferase 4; Gamma-glutamyltransferase 7; Gamma-glutamyltransferase-like 3; Gamma-glutamyltransferase-like 5; Gamma-glutamyltranspeptidase 7; gamma-glutamyltranspeptidase-like 3; GGT 7; Glutathione hydrolase 7; mFLJ00311 protein; unnamed protein product
基因别名: 1110017C11Rik; 6330563L03Rik; D20S101; GGT4; GGT7; GGTL3; GGTL5
UniProt ID: (Human) Q9UJ14, (Mouse) Q99JP7, (Rat) Q99MZ4
Entrez Gene ID: (Human) 2686, (Mouse) 207182, (Rat) 156275